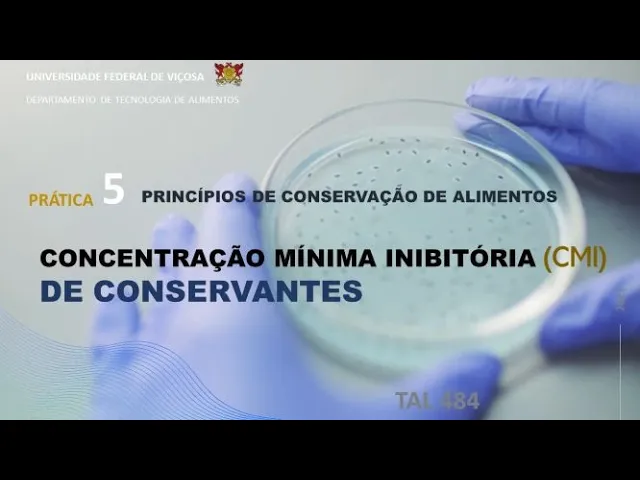

nós estamos de volta mais uma vídeo aula de princípios conservação dos alimentos na aula teórica de número 5 discutimos sobre os métodos químicos de conservação e aprofundamos nosso conhecimento sobre o mundo dos conservantes químicos na prática de hoje vamos conhecer uma das formas possíveis de avaliar se o conservante é efetivo sobre um determinado visualista e com a dose mínima que deve ser empregada para conseguir um efeito antimicrobiano para atingir o é só que lembrando os métodos químicos conservação podem ser entendidos como métodos ou tecnologia processamento dos quais substâncias químicas naturais ou sintéticas são intencionalmente adicionadas
com o único propósito de prolongado tempo de prateleira desse produto e quando falamos de substâncias químicas por essa definição Estamos nos referindo ao sal de cozinha ácidos orgânicos e inorgânicos e seus derivados também estamos falando de peptídeos e proteínas com ação antimicrobiana e e existem vários fatores que devemos levar em consideração na hora de escolher o desenvolver um novo conservante para aplicação em alimentos o primeiro passo é claro é verificar se a substância em questão não traz malefícios à saúde do Consumidor também não podemos nos esquecer do conservante não pode alterar as características do alimento
deve-se adequar a tecnologia de processamento e não pode ser caro o interagir com os componentes do produto formando substâncias tóxicas um desses fatores precisamos conhecer sobre qual ou quais microrganismos conservante efetivo e Qual a dose mínima precisamos usar para garantir o seu efeito bacteriostático e bactericida essa aula tem como finalidade que responder Essas duas últimas perguntas derivado do leite Qual é é o leite leite vaca derivado outras ovo que eu falei o que é E aí o objetivo Vamos aprender a determinar a concentração mínima de Vitória oxigenind para conservar e avaliar o efeito dos mesmos
só que diferentes microrganismos lembre-se que esse é o teste bem simples e somente a partir deles são é possível concluir se o conservante será efetivo quando aplicado a um produto no entanto essa técnica permite eliminados conservantes que apresentam baixa efetividade sobre determinado microrganismo au au e para essa demonstração prática vamos precisar de culturas nativas salmonella staphylococcus áureos e leveduras vamos precisar também de tubos contendo 5 ml de caldo nos clientes e prestadores de 100 e 1000 microlitros placas de Petri estéreis com água PCA Alcides legal ski etanol 95% bico de busen estufa a 37 graus
Celsius e o que não podemos esquecer o conservante que vamos testar e para essa aula serão os astros acético cíclico elástico e para realização dessa parte iremos colocar em série 10 tubos contendo 5 ml de cálculo cliente cabelo e vamos começar pelo ácido acético no primeiro tubo vamos adicionar 5 ml do aço Assim estaremos dividindo sua concentração pela metade E aí e depois disso pegamos 5 ml do primeiro tubo e passamos para o segundo tubo E aí E aí G1 E aí E aí Nós pegamos 5ml o segundo tubo e passamos para o terceiro turbo
o negão 5ml terceiro e passamos para o quarto e daí por diante faremos esse procedimento até chegarmos ao décimo turbo é uma vez que temos todos os 10 cubos de caldo nutriente contém crescentes concentrações de ácido acético iremos adicionar sem micro litros da cultura ativa de salmonella em cada tubo vamos agora recomeçar do zero adicionamos 5 ml de ácido acético no tubo 15 ml de caldo nutriente transferimos 5 ml do primeiro turno para o segundo 5 ml do segundo para o terceiro até chegarmos ao décimo tubo E agora temos uma nova série de 10 furos
o concentrações decrescentes de ácido acético e em cada tubo vamos adicionar sem micrômetros da cultura ativa staphylococcus altos vamos começar a Juiz Foz do ácido acético novamente e no final iremos adicionar sempre produtos da líder da tiva em cada tubo é uma vez que finalizamos o procedimento com ácido acético iremos que fazer todo esse trabalho usando o ácido lático e o síndico A diferença é que o ácido cítrico é comercializado na forma de cristais o e dessa maneira ao invés de adicionar 5 ml de Aço o primeiro tubo iremos adicionar 5 gramas do ácido é
uma vez que temos todos os tubos com seus respectivos atos e adicionados os microrganismos vamos pegar o mágico tá de 100 crônicos de cada um e depositar na superfície do HPC a feito isso fazemos o espalhamento com auxílio da alça de drigalski e seguimos as placas para incubação de 7 graus celsius e e no final temos a seguinte configuração dos experimentos três séries todos com ácido acético e lático e físico contendo as salmonelas a three tabs de 10 tubos com as suas ético plástico e cítrico contendo staphylococcus altos e três séries de 10 tubos com
ácido acético lá tipo específico contendo A levedura a avaliação dos resultados vamos deixar os tubos em cubano por 24 horas a quinta e 7 graus celsius e em seguida realizaremos a leituras os tubos em que houve turvação vamos chamar de positivos e os tubos em que não houve turbação chamaremos negativo nós vamos fazer a mesma coisa para as placas de Petri e foi incubadas nas placas pode crescer um colônias chamaremos o resultado de positivo e nas placas onde não houve o desenvolvimento de colônias vamos chamar o resultado de negativo e agora vamos aos resultados e
conversaremos pela salmonella nas favelas podemos ver os resultados para cada tipo de Aço emprestava agora vamos avaliar staphylococcus áureos a e por último temos os resultados Fábio três tipos de Aço usando A levedura como microrganismo ao e o grupo finalizando mais uma aula e é claro que perguntas na descrição desse vídeo agora para não ficar pegando um beleza e E aí [Música] E aí E aí